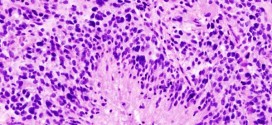

El angiosarcoma hepático. Tumor maligno en general y especialmente el formado por células epiteliales, a saber. El angiosarcoma hepático es un tipo de cáncer de hígado que aparece en las células de Kupffer y endoteliales que revisten a los vasos sanguíneos del hígado. La función normal de las células de Kupffer es filtrar bacterias y moléculas extrañas de la sangre …
Leer MásA
ASTEREOGNOSIA
La asterognosia. Imposibilidad de reconocer los objetos por el tacto a causa de alguna lesión en el lóbulo parietal, etc. Trastorno neurológico que se caracteriza por una incapacidad para identificar los objetos mediante el tacto. Imposibilidad de reconocer los objetos por el tacto a causa de una lesión en el lóbulo parietal o de una hemiplejía (trastorno del cuerpo del …
Leer MásALEXIA
La alexia. Es la Incapacidad de comprender el significado de los signos escritos (de lectura) debido a una alteración de los centros del cerebro ligados a la función léxica. La alexia se caracteriza por la incapacidad de leer textos y se produce a raíz de una lesión en la zona cerebral. Se trata de la pérdida de la habilidad de …
Leer MásADIPOMA
El adipoma. Tumor, quiste, etc; normalmente es benigno constituido por una masa circunscrita de tejido adiposo ó constituidos por la proliferación de tejido celular subcutáneo. Es un tumor, quiste, absceso, etc; benigno compuesto de tejido adiposo, a veces encapsulado que se manifiestan como masas redondas bien definidas con una pared visible y homogénea. Tiene un crecimiento lento de masa grasa …
Leer MásAUTOMATISMO
El automatismo. Ejecución de actos complejos con independencia de la voluntad o sin volición (acto de voluntad) consciente. Información: Para más información sobre esta enfermedad o patología, si usted cree que es necesario, preguntar a su médico o especialista, libros e inclusive en internet, donde encontraras cientos o miles de páginas, rellenitas de información, que seguramente ya sabe usted, pero …
Leer MásAXONOTMESIS
La axonotmesis. Lesión de las fibras nerviosas sin que se produzca una sección completa del nervio. Lesión nerviosa que conserva la continuidad del nervio; degeneran las vainas mielínicas y los axones, pero las estructuras conjuntivas del nervio permanecen intactas. Axonotmesis es la ruptura y discontinuidad del axón debido a una herida en el nervio. En la axonotmesis la herida rompe …
Leer MásANACROASIS
La anacroasis. Trastorno e imposibilidad de comprender el lenguaje hablado, sin que esté afectado la comprensión del lenguaje escrito. La Trofología avanzada cuenta también con un sistema fabuloso de restauración y regeneración Neurológica como lo es: TRNTA (Terapia de Restauración Neurológica Trofológica Avanzada): Es una estrategia terapéutica que combina métodos de la Trofología avanzada que basándose en las propiedades …
Leer MásALBUGO
El albugo. Mancha blanca de naturaleza adiposa que se forma en la córnea. Trastorno trófico de las uñas en las que aparecen pequeñas manchas blancas transversales. Para todas estas patologías la madre naturaleza nos regala sus dones más preciados para nuestra salud y recuperación y bienestar. Prueba de ello los extraordinarios resultados que se obtienen con la binipatia y su …
Leer MásALBINISMO
El albinismo. Ausencia hereditaria recesiva del pigmento cutáneo. Falta congénita total o parcial de pigmentación de la piel y órganos relacionados como el cabello y la pupila y ocular. Es debido a la falta del enzima tirosina, encargado de transformar la tirosina en melanina. La ausencia de pigmento en los ojos provoca fotofobia, etc. Debería de saber qué: Cuando …
Leer MásAUSENCIA
La ausencia. Pérdida muy breve del conocimiento (de 2 a 15 segundos) que acompaña ciertas descargas epilépticas generalizadas y se producen antes de ciertos ataques de epilepsia. La mayoría de las ausencias típicas duran sólo unos pocos segundos y con mayor frecuencia involucran episodios de mirada fija o «ausencias». Alteración temporal de la función cerebral, ocasionada por una actividad eléctrica …
Leer MásAMIMIA MOTRIZ
La amimia motriz. Incapacidad para llevar a cabo gestos. Incapacidad para expresarse mediante la mímica o los gestos (amimia motriz), o bien para comprender el significado de la mímica o los gestos de los demás (amimia sensorial). La Trofología avanzada cuenta también con un sistema fabuloso de restauración y regeneración Neurológica como lo es: TRNTA (Terapia de Restauración Neurológica …
Leer MásANGIOSARCOMA DE MAMA
El angiosarcoma de mama. Maligno en general y especialmente los formados por células epiteliares. Durante los primeros años de vida de una persona, las células normales se dividen más rápidamente para permitir el crecimiento. El cuerpo está compuesto por billones de células vivas. Las células normales del cuerpo crecen, se dividen formando nuevas células y mueren de manera ordenada. Una …
Leer MásATAXIA TELANGIECTASIA
La ataxia telangiectasia, también llamado (Síndrome de Louis-bar). La ataxia telangiectasia (AT) es una enfermedad genética, causada por una mutación en el gen ataxia-telangiectasia mutado (ATm), de transmisión autosómica recesiva, que se localiza en el brazo largo del cromosoma 11. El gen afectado codifica una enzima del tipo fosfatidilinositol quinasa tipo 3 implicada en el control del ciclo celular. Es …
Leer MásAURA
El aura. Sensación pasajera que precede una enfermedad o paroxismo, especialmente un ataque epiléptico. Puede producirse por vía motora, sensorial, vasomotora, auditiva, olfativa, visual o psíquica. La Trofología avanzada cuenta también con un sistema fabuloso de restauración y regeneración Neurológica como lo es: TRNTA (Terapia de Restauración Neurológica Trofológica Avanzada): Es una estrategia terapéutica que combina métodos de la …
Leer MásASTASIA
La astasia. Incoordinación motora o imposibilidad de permanecer de pie debido a una falta de coordinación motora. Imposibilidad de guardar el equilibrio en posición de pie, aunque no existe ningún déficit ni trastorno de la coordinación. Enfermedad nerviosa que impide al individuo mantenerse en posición vertical. Astasia es una forma de Trastorno disociativo en el cual se convierte en deterioro …
Leer MásANGIOLUPOIDE
El angiolupoide. Lesión cutánea de carácter tuberculoso con forma de placas redondeadas y rojizas que aparece preferentemente en la nariz y las manos. Forma cutánea de sarcoidosis: enfermedad sistémica crónica (a saber), caraterizada histológicamente por una reacción inflamatoria granulomatosa no necrotizante. A saber. Granuloma localizado en la nariz, de color violáceo, con telangiectasias que semejan al lupus. Para todas estas …
Leer MásALGODISFROFIA SIMPÁTICA
La algodistrofia simpática. Neuralgia caraterizada por u conjunto de fenómenos circulatorios y de dolor intenso que se producen en un miembro superior debido a una alteración en el sistema simpático, como el síndrome hombro-mano, la causalgia y el síndrome postraumático. Afección del sistema nervioso central, cerebral, etc, de probable patogenia autoinmune, etc, que se caracteriza por placas de desmielinizacion seguidas …
Leer MásATEROMA ARTERIAL
El ateroma arterial. Enfermedad ateromatosa (afecto de ateroma (depósito de lípidos en la pared arterial con producción de masas amarillentas de induración y reblandecimiento, que se observa en la aterosclerosis) o de su naturaleza) difusa de las arterias. Resumiendo: Acumulación local de fibras y lípidos, principalmente colesterol, en la pared interna de una arteria. Se forma una placa que estrecha …
Leer MásARTERITIS DE LOS MIEMBROS INFERIORES
La arteritis de los miembros inferiores. Dureza y engrosamiento anormales de las paredes arteriales, resultado de inflamaciones, especialmente de la túnica íntima con tendencia a la obliteración del vaso. Enfermedad de los vasos arteriales de etiología diversa que provocan una obliteración o estrechez que obstruye el orificio de las arterias, disminuyendo el flujo sanguíneo arterial. Esta es una enfermedad que …
Leer MásARTERIOSCLEROSIS DE MÖNCKEBERG
Arteriosclerosis de mönckeberg. Dureza y engrosamiento anormales de las paredes arteriales, resultado de inflamaciones, especialmente de la túnica íntima con tendencia a la obliteración del vaso. Compromete la capa media de las grandes arterias principalmente de los miembros y se caracteriza por fibrosis y calcificación de las mismas sin estenosis significativa ni isquemia pero facilita la formación de aneurismas. Ocurre …
Leer Más Binipatia e higienismo Medicina natural alternativa, plantas medicinales y remedios caseros naturales
Binipatia e higienismo Medicina natural alternativa, plantas medicinales y remedios caseros naturales